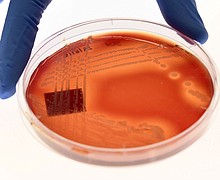

Study presents unexpected — and complicated — findings on link between alcohol and dementia
Keeping alcohol consumption to one or two drinks a day lessened the odds of developing dementia, according to a study of nearly 4 million South Koreans.
Despite recent widespread illness in US, Covid-19, flu and RSV are not a concern for most, survey finds
Respiratory viruses -- including the flu, RSV and the virus that causes Covid-19 -- are not a serious concern for most of the US public, even though they're still affecting many, according to new survey data from the Kaiser Family …
The fungal threat to human health is growing in a warmer, wetter, sicker world
In the HBO show "The Last of Us," characters identify zombies among them by the fungi that bursts from their bodies, and fungal parasites manipulate the humans to infect the communities around them.
Climate change is contributing to the rise of superbugs, new UN report says
Climate change and antimicrobial resistance are two of the greatest threats to global health, according to a new report from the United Nations Environment Programme.
The one thing that can improve your sex life, according to this couple
The timeless advice for couples about the importance of communicating when it comes to sex might be as old as the act itself.
For the first time, US task force proposes expanding high blood pressure screening recommendations during pregnancy
The US Preventive Services Task Force has released a draft recommendation to screen everyone who is pregnant for hypertensive disorders of pregnancy, by monitoring their blood pressure throughout the pregnancy, and the group is calling attention to racial inequities.
Don't serve Girl Scout cookies with a side of shame
It's Girl Scout cookie season again, which means young female entrepreneurs are outside your favorite stores and community centers selling you the latest flavors and old favorites.
Could you still have Covid-19 if you have symptoms but test negative? A medical analyst weighs in
It has been over three years since Covid-19 cases were first diagnosed in the United States. And while President Joe Biden announced last week that he intends to end the state of national emergency around Covid-19, this does not mean …
Health experts call for an end to exploitative baby formula milk marketing tactics
Less than half of infants around the world are breastfed as recommended, and baby formula is in high demand despite failing to offer the same health and developmental benefits as breast milk, experts say. According to a new report, misleading …
'It's an art form': Drag queen who performed at Diversity Breakfast pushes back on anti-drag legislation
Columbia's 2023 Columbia Values Diversity Celebration received pushback from both Columbia Public School parents and state legislators. Now, one of the drag performers at the breakfast is speaking out against legislation aimed to restrict drag shows in the state.
Fears of contaminated water and air fester where a derailed train carrying a toxic chemical burned
The flames may have died down, but a cloud of anxiety now wafts through East Palestine, Ohio.
Lockerbie bombing suspect pleads not guilty to charges connected to 1988 terrorist attack
A Libyan man accused of being involved in making the bomb that destroyed Pan Am Flight 103 over the town of Lockerbie, Scotland, in December 1988 pleaded not guilty on Wednesday to three federal charges brought against him in Washington, …
Selfie taken by Gabby Petito shows she had a facial injury on the day she was interviewed by Moab police over domestic disturbance call, lawyer says
A selfie taken by Gabby Petito weeks before her death shows she had facial injuries on the day she and her fiancé, Brian Laundrie, were stopped by police investigating a domestic disturbance call, according to her family's lawyer.
Justice Department recommends improvements in training, hiring and accountability for Columbus, Ohio, police department
The US Department of Justice has released its recommendations for reform of the Columbus, Ohio, police department following a nearly two-year review process.
Discovery+ is sticking around. It's a strategy shift for Warner Bros. Discovery
Discovery+ isn't disappearing, after all. Warner Bros. Discovery, CNN's parent company, has decided to continue offering the Discovery+ streaming platform in the United States, according to a source familiar with the company's plans. That marks a sharp reversal from the …